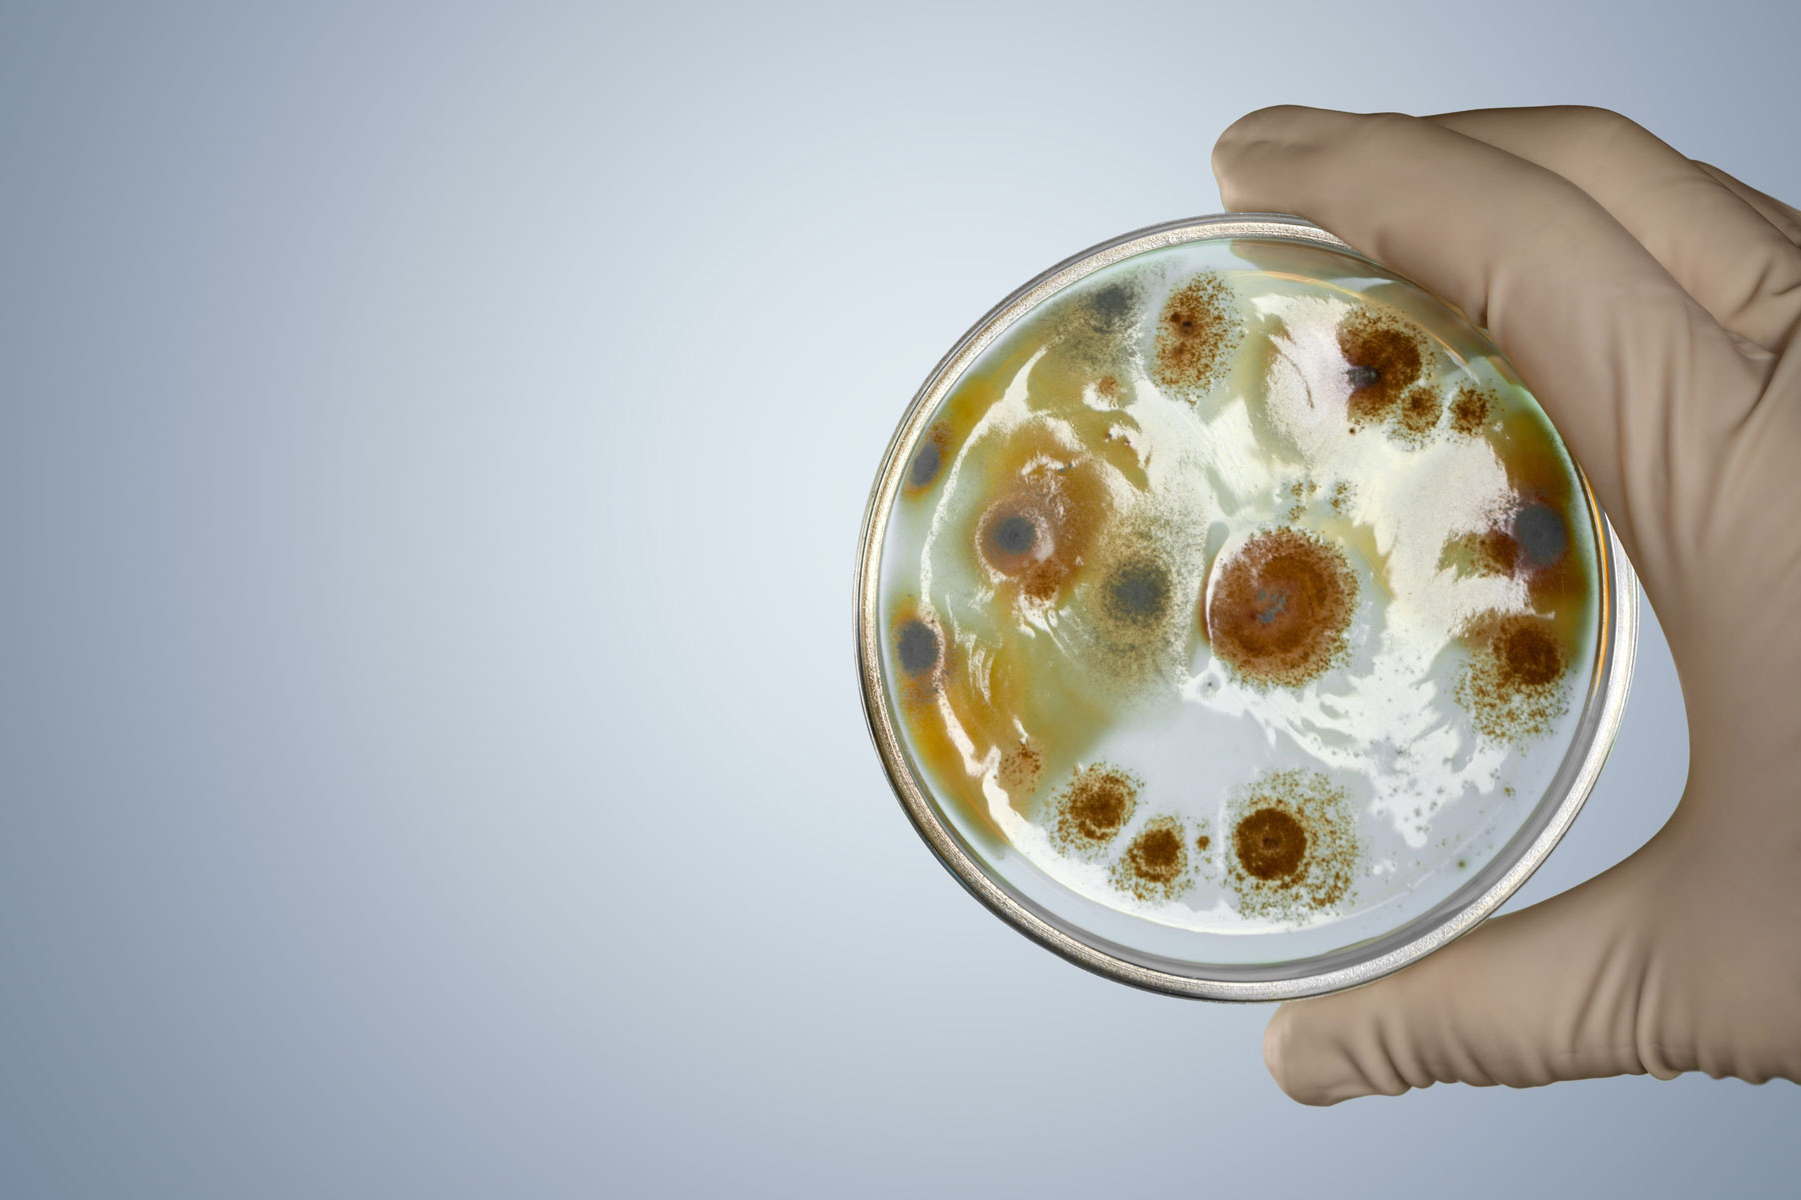
cultura em placa

COMO PREVENIR AS CÓLICAS
UTILIZANDO OS SIMBIÓTICOS
Uma das principais causas de cólica de origem nutricional nos equinos ocorrem pela alta produção de gás no intestino decorrentes do processo fermentativo. As bactérias fermentam os açucares livres e produzem ácido lático e gás.
Quando quantidades significativas desses açucares livres atingem o ceco e cólon grande quantidade de gás será produzido e caso este gás não seja eliminado pelo ânus e o gás distenderá o intestino levando a dor, problemas circulatórios e alterações na motilidade intestinal.
Dietas ricas em amido são as maiores causas de cólicas porque promovem o crescimento exagerado de determinadas bactérias. Os probióticos devolverão o equilíbrio perdido.

PROBIÓTICOS MELHORAM A
QUALIDADE DO CASCO
As bactérias fermentam os açucares livres e produzem ácido lático e gás. Quando quantidades significativas desses açucares livres atingem o ceco e cólon grande quantidade de ácido lático será produzido pelas bactérias fermentadoras como o Lactobacillus, Lactococos, etc. O ácido lático é um ácido forte que baixará o pH.
As bactérias fibrolíticas muito importante na digestão dos alimentos ricos em fibra (fenos e pastagens) são efetivas em pH neutro. Em pH menores que o ideal a atividade destes micróbios será menos efetiva e haverá diminuição da produção de vitaminas hidrossolúveis (Vitaminas do complexo B). A Biotina, também conhecida como vitamina B7, é fundamental para a saúde do casco, pois garante uma produção de queratina de alta qualidade.

PROBIÓTICOS PARA OS CAVALOS ATLÉTAS
As bactérias fermentam os açucares livres e produzem ácido lático, gás e energia. Quando quantidades significativas desses açucares livres atingem o ceco e cólon grande quantidade de ácido lático será produzido pelas bactérias fermentadoras como o Lactobacillus, Lactococos, etc. O ácido lático é um ácido forte que baixará o pH. As bactérias fibrolíticas muito importante na digestão dos alimentos ricos em fibra (fenos e pastagens) são efetivas em pH neutro.
Em pH menores que o ideal a atividade destes micróbios será menos efetiva e haverá diminuição na digestão das fibras. A digestão da fibra é fundamental para fornecer energia para os animais atletas. Existem fibras, como a Pectina, que geram energia parecida com os grãos. Portanto a energia gerada pelos volumosos ajuda a suprir as demandas dos animais atletas e mantem o intestino funcional.

AUMENTO NA EFICIENCIA DA
ALIMENTAÇÃO COM FIBRAS
Os equinos são naturalmente herbívoros e a eficiência da digestão das fibras determinará que os animais tenham mais saúde e o custo da dieta seja mais barata.
A fibra gera grandes quantidades de energia, mas é dependente de uma microbiota saudável para que seja aproveitada. As leveduras presentes no SIM PLUS impedem oscilações no pH intestinal o que garante um ambiente adequando aos microorganismos intestinais.
Além de propiciar a digestão das fibras e gerar grande quantidade de energia as bactérias produzem todas as vitaminas do complexo B que os cavalos necessitam. Cavalos com saúde intestinal possuem cascos mais fortes e saudáveis, apresentam pelagem brilhante e terão aumento na eficiência reprodutiva.

PROBIÓTICOS
Em equídeos, os probióticos são utilizados para tentar estabelecer um equilíbrio desejável entre os microrganismos intestinais, principalmente aqueles benéficos.
Atualmente, vários microrganismos são usados como probióticos, sendo os mais comuns os do gênero Lactobacillus, Bifidobacterium, Streptococcus, além das leveduras vivas como a Saccharomyces cerevisiae (OITICICA et al., 2007).
O equilíbrio entre os microorganismos intestinais é determinado pela dieta. Erros nutricionais como rações ricas em amido prejudicarão o bioma intestinal e o resultado será baixa produção de vitaminas do complexo B, menor produção de energia, baixa da imunidade e liberação de alérgenos para o organismo animal.
Probióticos e as Dermatites por Lambedura
A Dermatite por Lambedura ou Psicogênica tem um fundo alérgico e pode estar associado a outras doenças. A incidência destes problemas vem aumentando nas últimas décadas e está associada a mudanças no estilo de vida e ambiente, possivelmente devido a diminuição da exposição dos animais às bactérias benéficas presentes no ambiente natural e que modulam o sistema imune dos pets.
Então os pets que vivem em ambiente rural possuem menor probabilidade de desenvolverem a doença. Animais solitários, sem estímulos e aborridos tem o quadro agravado. Sabe-se que há forte componente genético na predisposição a esta enfermidade, isso quer dizer que determinadas raças e ninhadas estão mais propensas a desenvolverem o problema de pele. Quando equilibramos a “flora” (microbioma) intestinal haverá diminuição da liberação de fatores que desencadeiam a dermatite, Diminuindo o ímpeto para se lamber.

